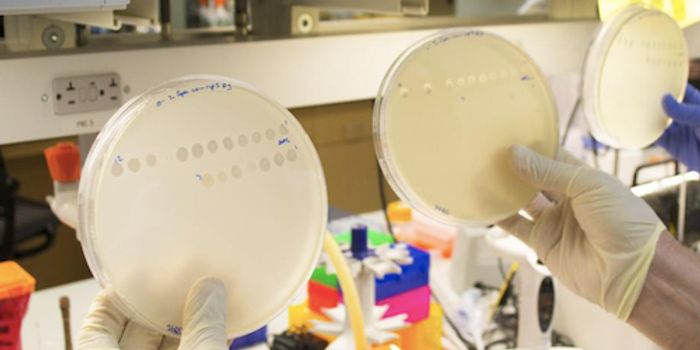
A Newly Discovered Evolutionary Pathway in Viruses

Virus structure
The structure of a virus contains four major components: 1) the genome, 2) the capsid, 3) the envelope, 4) enzymes. Viruses can only maintain their structure and function by deriving energy from a host cell which occurs upon infection.
-
JAN 07, 2019ImmunologyUniversity of Nebraska-Lincoln researchers may have identified a vaccine that would defend against Zika virus without pr ...Written By: Nicholas BreehlDEC 26, 2018ImmunologyA team from Scripps Research has found a molecular cause of a group of rare autoimmune disorders in which the immune sys ...Written By: Nicholas BreehlDEC 20, 2018Health & MedicineCervical cancer is the fourth most common cancer found in women, globally, for incidence (6.6%) and mortality (7.5%). It ...Written By: Dena ArutaDEC 15, 2018Drug Discovery & DevelopmentIn a study published in Cell, research at Northwestern University School of Medicine has involved scientists discov ...Written By: Nouran AminDEC 04, 2018ImmunologyA team of scientists discover unique immune reactions to the one percent of HIV infected patients that are able to fend ...Written By: Nicholas BreehlNOV 28, 2018ImmunologyEnzymes identified that are responsible for methylation that will play a role in the production of immune cytokine molec ...Written By: Nicholas BreehlOCT 11, 2018Chemistry & PhysicsLast Wednesday, Oct 3rd, the Royal Swedish Academy of Sciences announced the winners of 2018 Nobel Prize in Chemistry: F ...Written By: Daniel DuanSEP 17, 2018Cell & Molecular BiologyScientists have developed a better way to create astrocytes, a cell type hat has been implicated in neurodegenerative di ...Written By: Carmen LeitchAUG 06, 2018ImmunologyMaternal Dengue immunity produces CD8+ T cells that protect against fetal Zika infection preventing zika-related malform ...Written By: Caitlin WilliamsJUN 27, 2018Drug Discovery & DevelopmentXofluza, the recent 24-hour killing flu drug that was developed by the Japanese pharmaceutical company Shionogi and appr ...Written By: Nouran AminJUN 12, 2018Genetics & GenomicsResearchers have discovered something incredible about giant viruses.Written By: Carmen LeitchMAY 02, 2018ImmunologyThe measles virus was caught leaving infected cells by the scientific paparazzi, that is, experts from Emory Health Scie ...Written By: Kara MarkerMAR 31, 2018MicrobiologyScientists have learned more about how viruses are able to change to fit into their environment; they use a previously u ...Written By: Carmen LeitchMAR 24, 2018Drug Discovery & DevelopmentA recent study showcased in the Society of Interventional Radiology Annual Scientific Meeting explains that liver Tumors ...Written By: Nouran AminJAN 10, 2018ImmunologyFor the first time, scientists have been able to gather evidence for a new antibody-based drug to treat people infected ...Written By: Kara MarkerJAN 09, 2018Drug Discovery & DevelopmentResearchers have discovered a path toward virus-like, nanoscale devices that may be able to deliver drugs to cells by ch ...Written By: The Scripps Research Institute (TSRI)JAN 08, 2018ImmunologyThe Zika virus is notorious for its deleterious effects on pregnancy, whether through causing miscarriages or birth defe ...Written By: Kara MarkerNOV 27, 2017ImmunologyOne of the viruses responsible for the itchy and runny nose, headache, and sore throat we associate with the common cold ...Written By: Kara MarkerNOV 21, 2017Drug Discovery & DevelopmentWe are using 3D organoids to unravel new therapies for a broad spectrum of human diseaseWritten By: Courtney SchaalNOV 21, 2017TechnologyFoldit is a computer game that uses human ingenuity and "problem-solving intuition" to explore the behaviors of proteins ...Written By: Julia TraversNOV 18, 2017Drug Discovery & DevelopmentScientists in Europe Use Genetically Modified Patient Stem Cells to Graft Whole Body SkinWritten By: Courtney SchaalNOV 14, 2017ImmunologyThe Zika virus is mostly portrayed in the media as an ultra dangerous infection that causes all sorts of problems in tho ...Written By: Kara MarkerNOV 02, 2017Clinical & Molecular DXPSA: Rabies is not a minor illness that will go away on its own. One person in Florida recently contracted rabies from a ...OCT 30, 2017Cell & Molecular BiologyScientists have been trying to develop a vaccine for HIV for many years, but unusual characteristics of the virus have m ...Written By: Carmen Leitch
JAN 07, 2019
Immunology
University of Nebraska-Lincoln researchers may have identified a vaccine that would defend against Zika virus without pr
...
Written By:
Nicholas Breehl
DEC 26, 2018
Immunology
A team from Scripps Research has found a molecular cause of a group of rare autoimmune disorders in which the immune sys
...
Written By:
Nicholas Breehl
DEC 20, 2018
Health & Medicine
Cervical cancer is the fourth most common cancer found in women, globally, for incidence (6.6%) and mortality (7.5%). It
...
Written By:
Dena Aruta
DEC 15, 2018
Drug Discovery & Development
In a study published in Cell, research at Northwestern University School of Medicine has involved scientists discov
...
Written By:
Nouran Amin
DEC 04, 2018
Immunology
A team of scientists discover unique immune reactions to the one percent of HIV infected patients that are able to fend
...
Written By:
Nicholas Breehl
NOV 28, 2018
Immunology
Enzymes identified that are responsible for methylation that will play a role in the production of immune cytokine molec
...
Written By:
Nicholas Breehl
OCT 11, 2018
Chemistry & Physics
Last Wednesday, Oct 3rd, the Royal Swedish Academy of Sciences announced the winners of 2018 Nobel Prize in Chemistry: F
...
Written By:
Daniel Duan
SEP 17, 2018
Cell & Molecular Biology
Scientists have developed a better way to create astrocytes, a cell type hat has been implicated in neurodegenerative di
...
Written By:
Carmen Leitch
AUG 06, 2018
Immunology
Maternal Dengue immunity produces CD8+ T cells that protect against fetal Zika infection preventing zika-related malform
...
Written By:
Caitlin Williams
JUN 27, 2018
Drug Discovery & Development
Xofluza, the recent 24-hour killing flu drug that was developed by the Japanese pharmaceutical company Shionogi and appr
...
Written By:
Nouran Amin
JUN 12, 2018
Genetics & Genomics
Researchers have discovered something incredible about giant viruses.
Written By:
Carmen Leitch
MAY 02, 2018
Immunology
The measles virus was caught leaving infected cells by the scientific paparazzi, that is, experts from Emory Health Scie
...
Written By:
Kara Marker
MAR 31, 2018
Microbiology
Scientists have learned more about how viruses are able to change to fit into their environment; they use a previously u
...
Written By:
Carmen Leitch
MAR 24, 2018
Drug Discovery & Development
A recent study showcased in the Society of Interventional Radiology Annual Scientific Meeting explains that liver Tumors
...
Written By:
Nouran Amin
JAN 10, 2018
Immunology
For the first time, scientists have been able to gather evidence for a new antibody-based drug to treat people infected
...
Written By:
Kara Marker
JAN 09, 2018
Drug Discovery & Development
Researchers have discovered a path toward virus-like, nanoscale devices that may be able to deliver drugs to cells by ch
...
Written By:
The Scripps Research Institute (TSRI)
JAN 08, 2018
Immunology
The Zika virus is notorious for its deleterious effects on pregnancy, whether through causing miscarriages or birth defe
...
Written By:
Kara Marker
NOV 27, 2017
Immunology
One of the viruses responsible for the itchy and runny nose, headache, and sore throat we associate with the common cold
...
Written By:
Kara Marker
NOV 21, 2017
Drug Discovery & Development
We are using 3D organoids to unravel new therapies for a broad spectrum of human disease
Written By:
Courtney Schaal
NOV 21, 2017
Technology
Foldit is a computer game that uses human ingenuity and "problem-solving intuition" to explore the behaviors of proteins
...
Written By:
Julia Travers
NOV 18, 2017
Drug Discovery & Development
Scientists in Europe Use Genetically Modified Patient Stem Cells to Graft Whole Body Skin
Written By:
Courtney Schaal
NOV 14, 2017
Immunology
The Zika virus is mostly portrayed in the media as an ultra dangerous infection that causes all sorts of problems in tho
...
Written By:
Kara Marker
NOV 02, 2017
Clinical & Molecular DX
PSA: Rabies is not a minor illness that will go away on its own. One person in Florida recently contracted rabies from a
...
OCT 30, 2017
Cell & Molecular Biology
Scientists have been trying to develop a vaccine for HIV for many years, but unusual characteristics of the virus have m
...
Written By:
Carmen Leitch